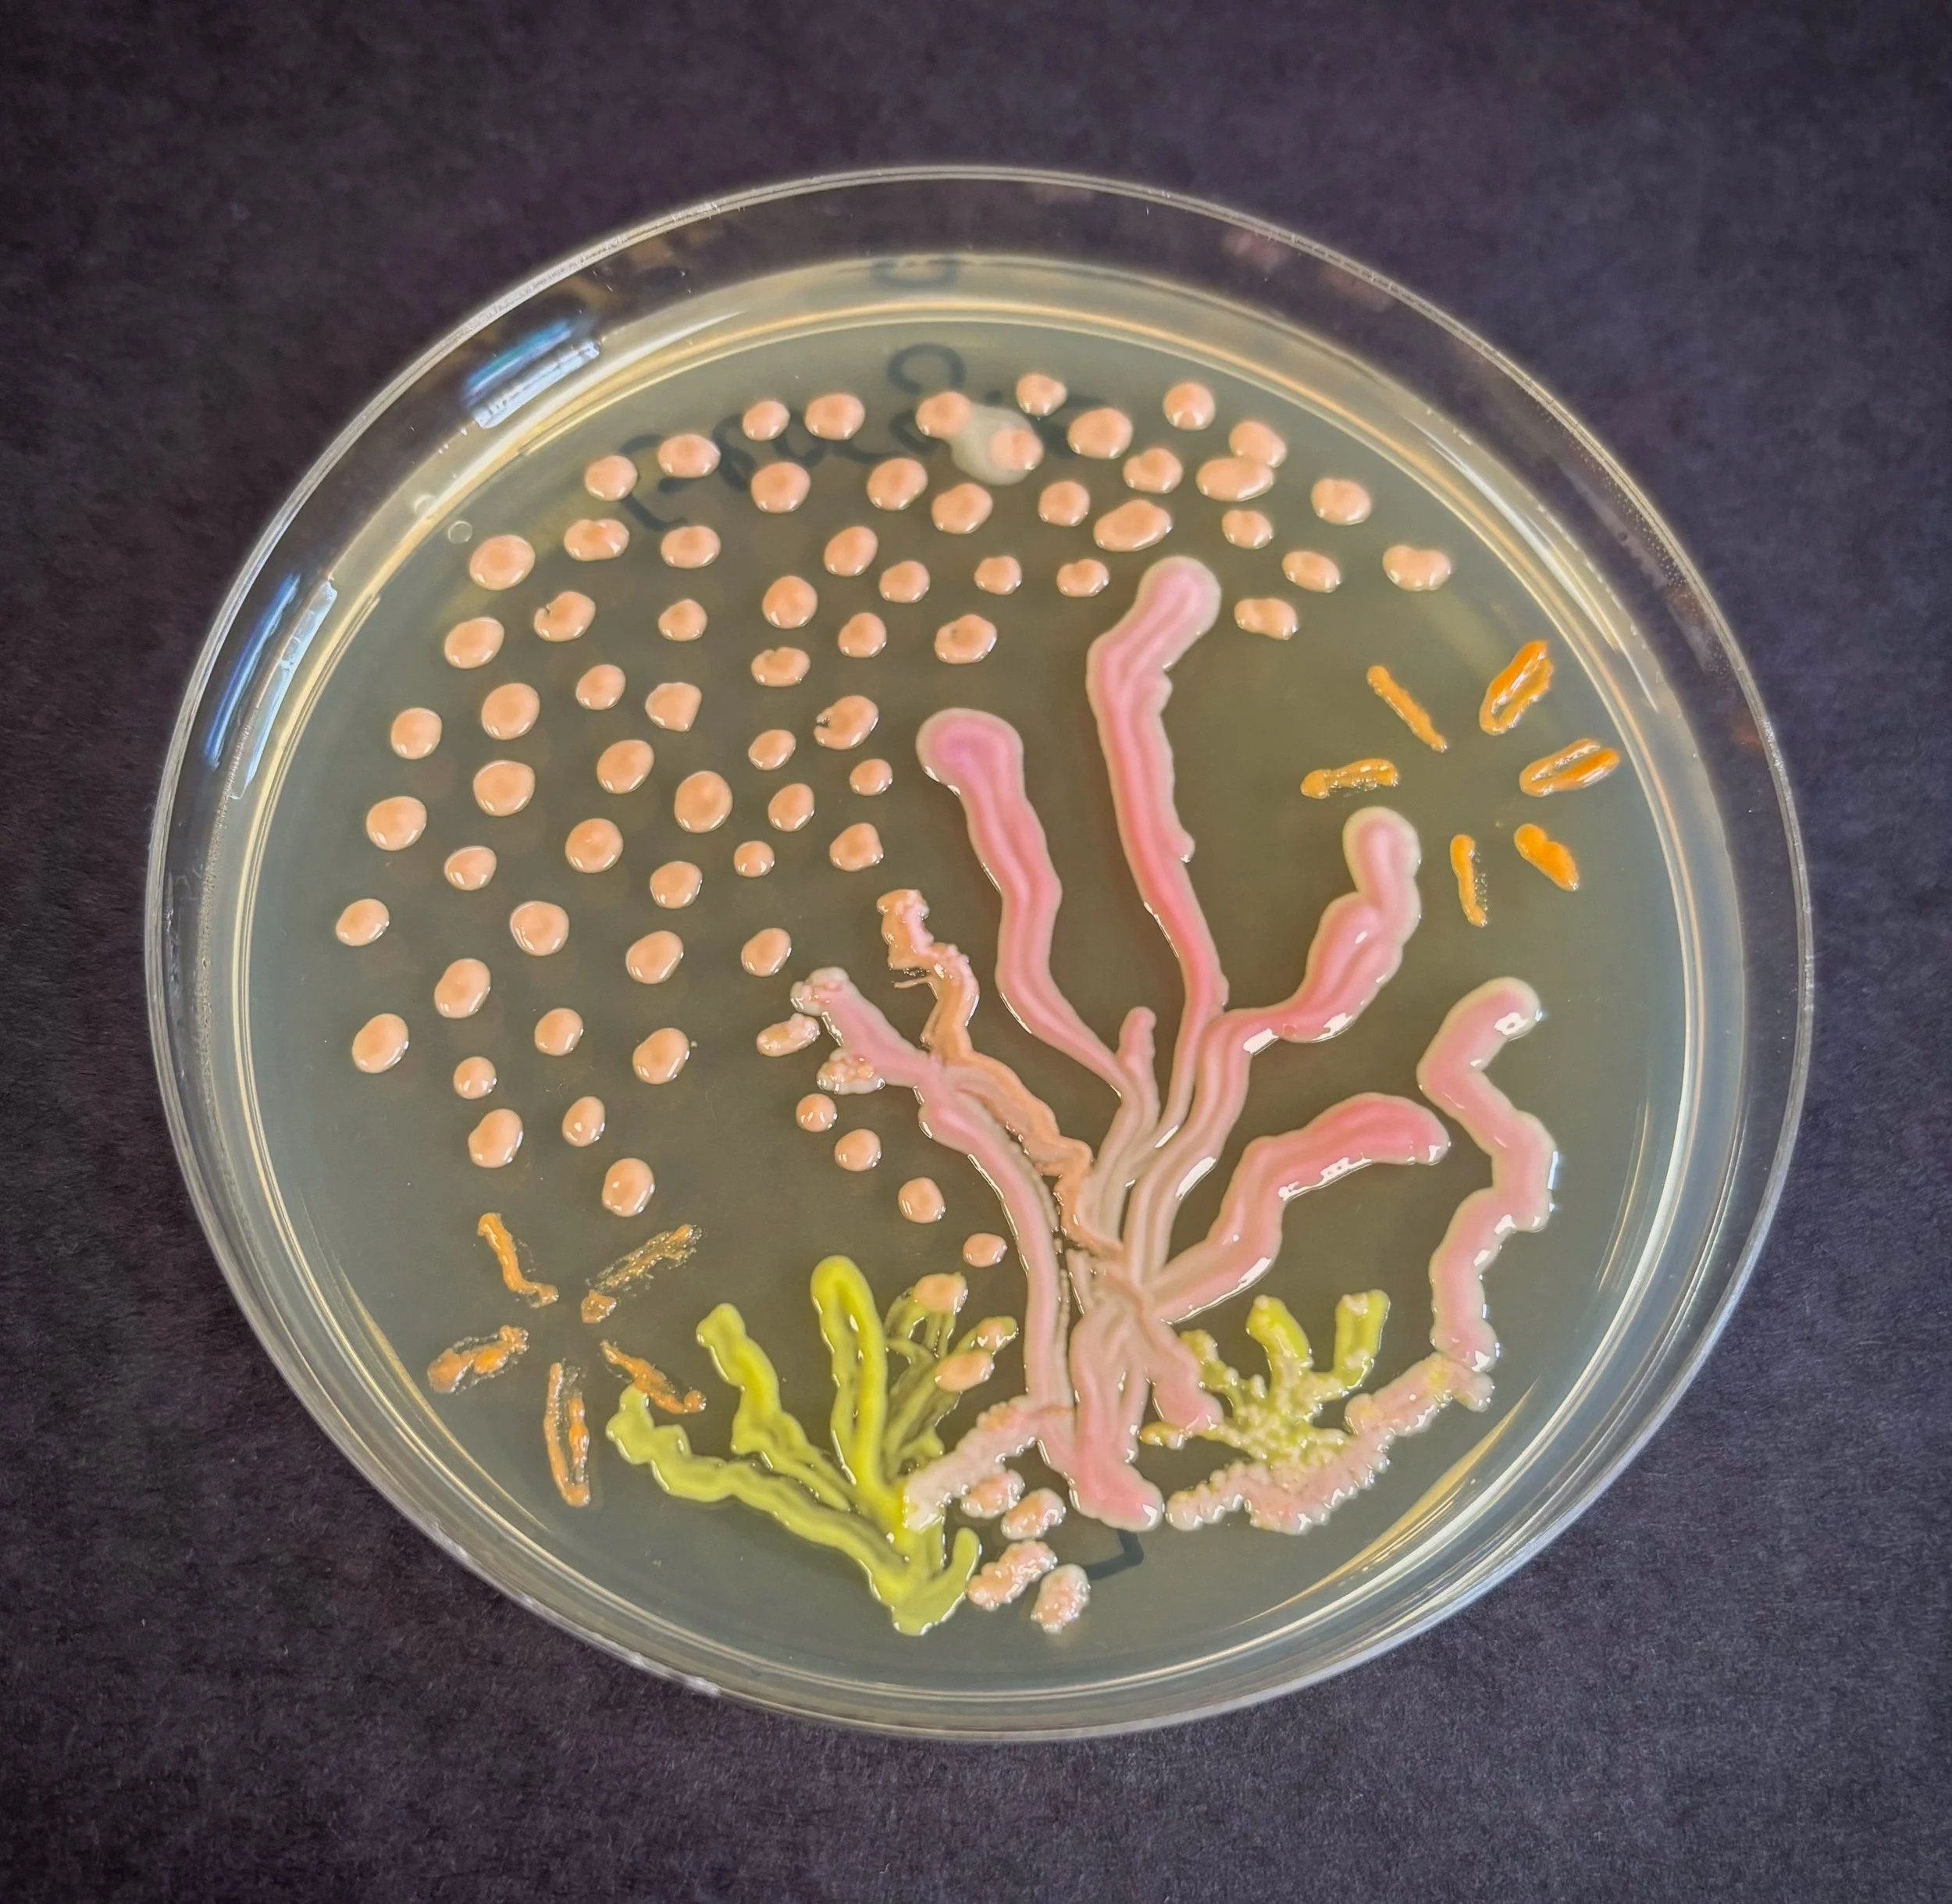
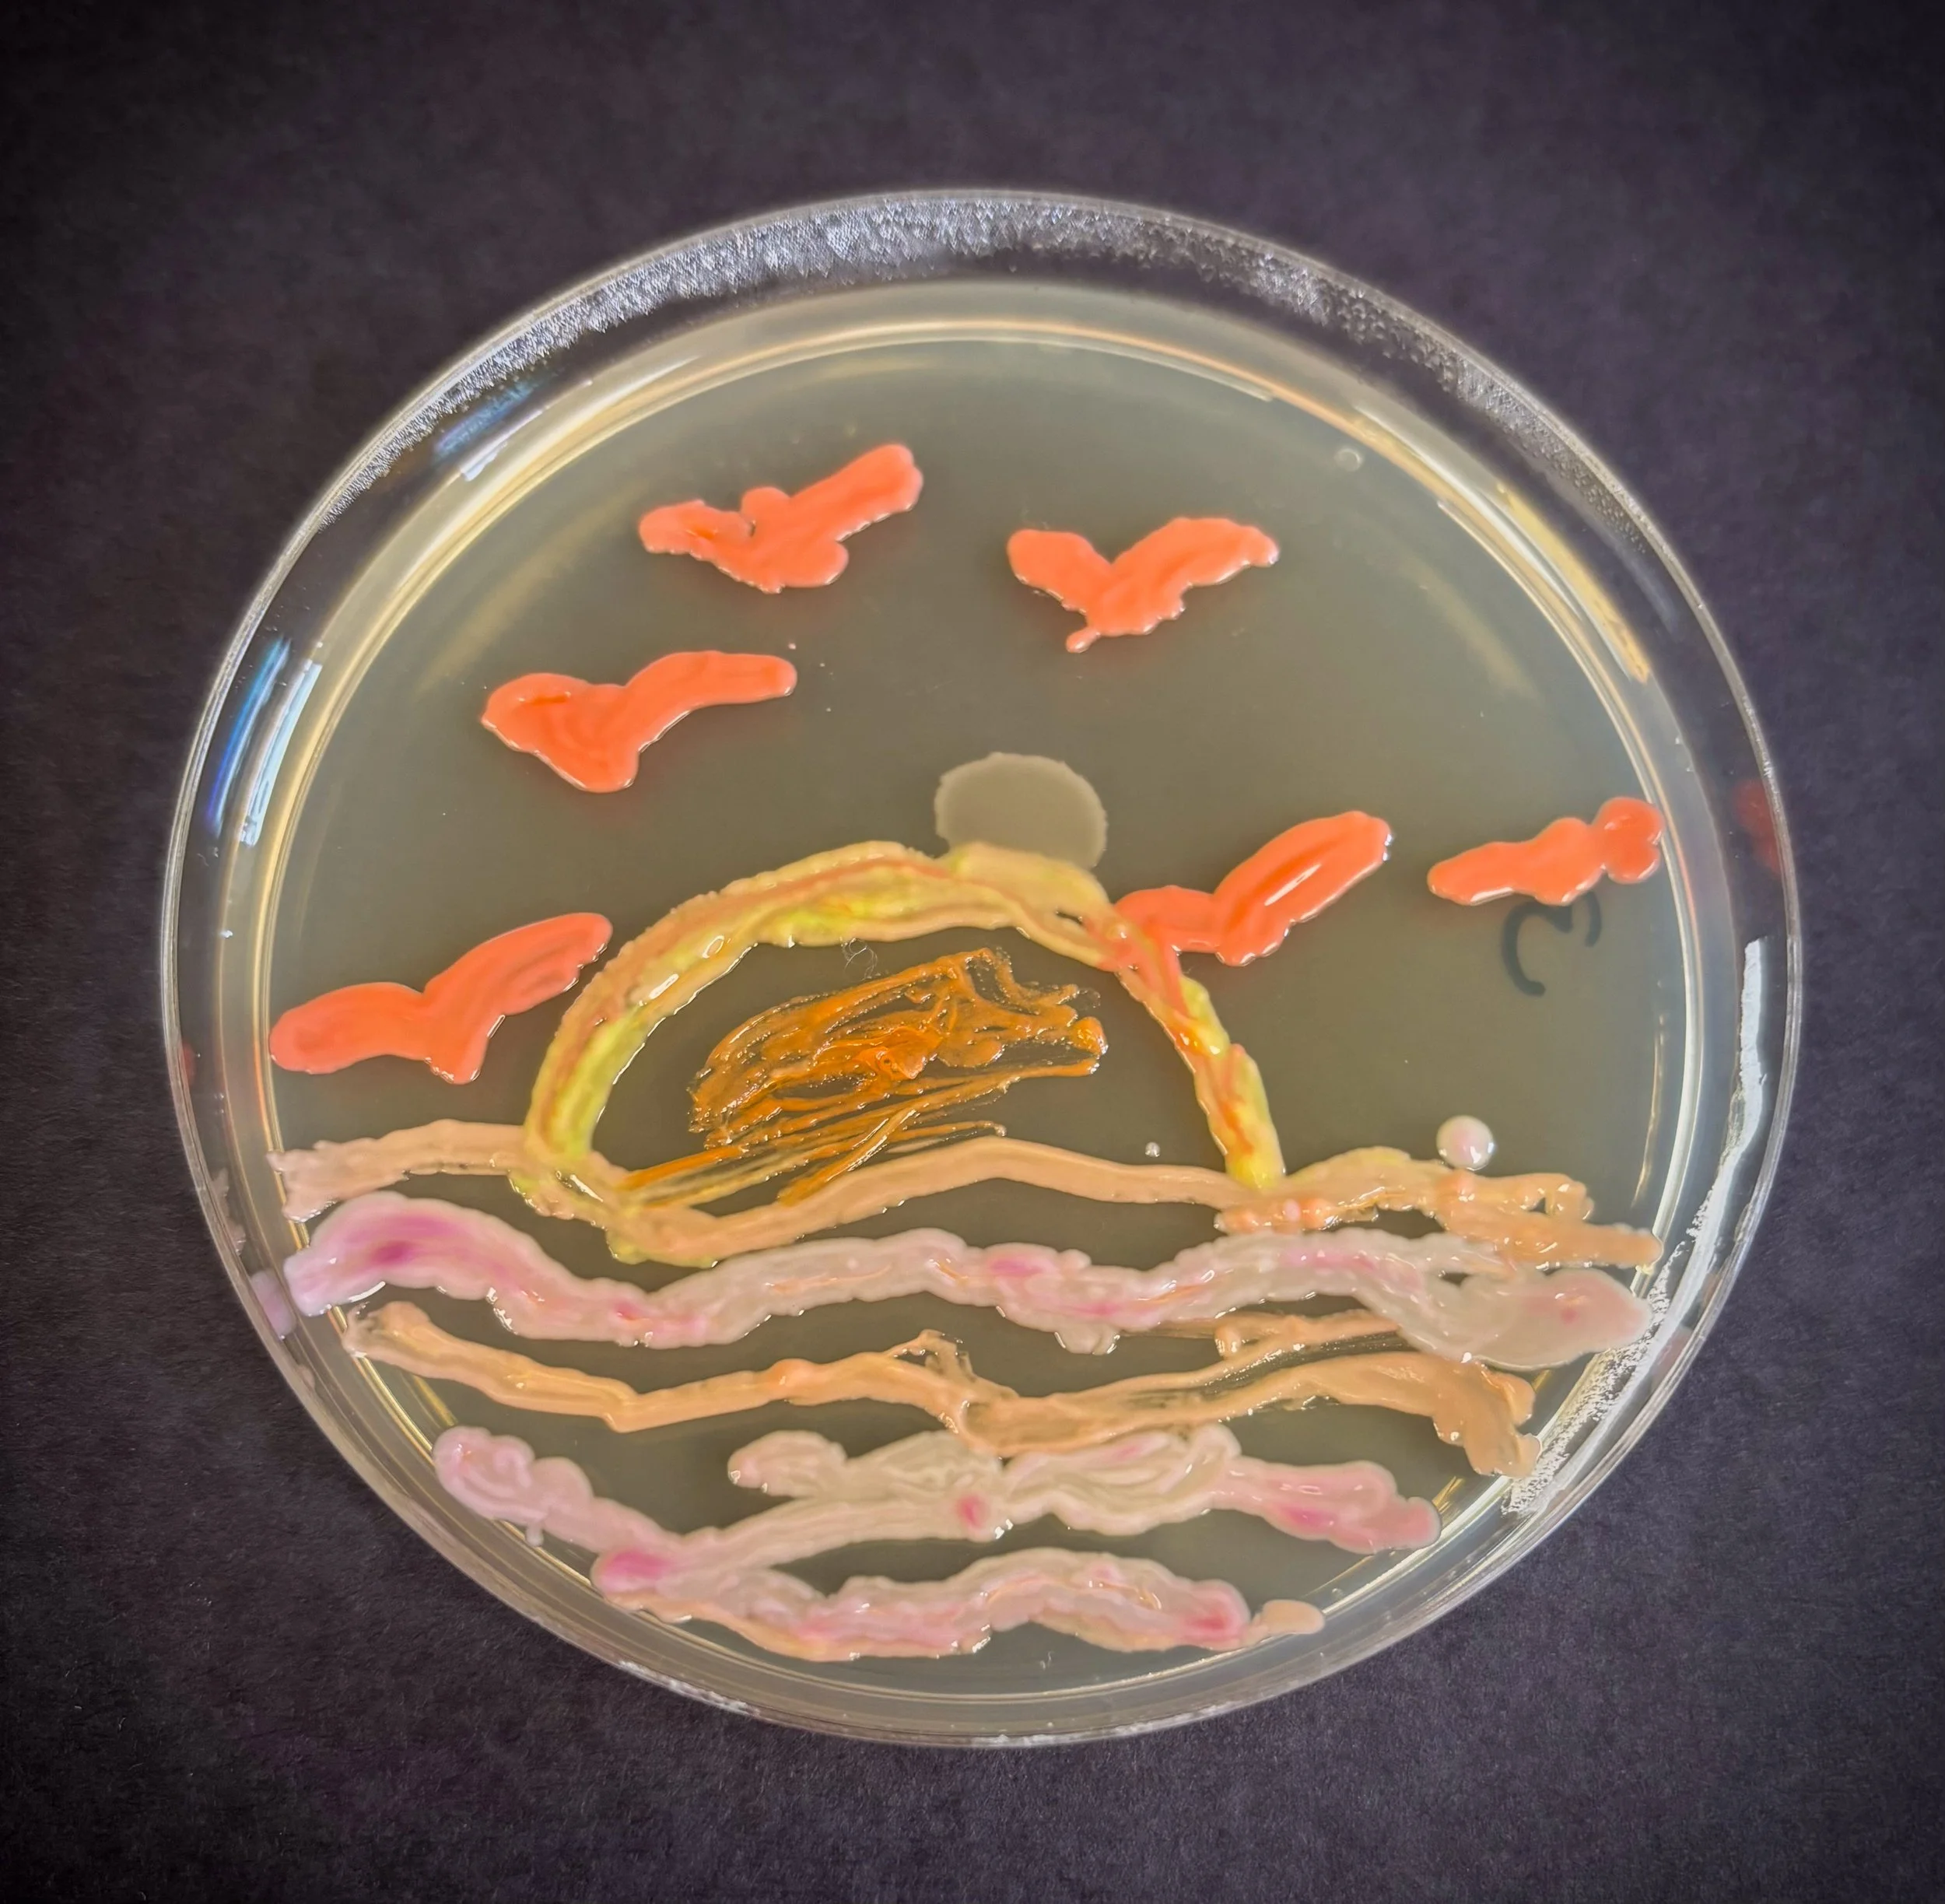
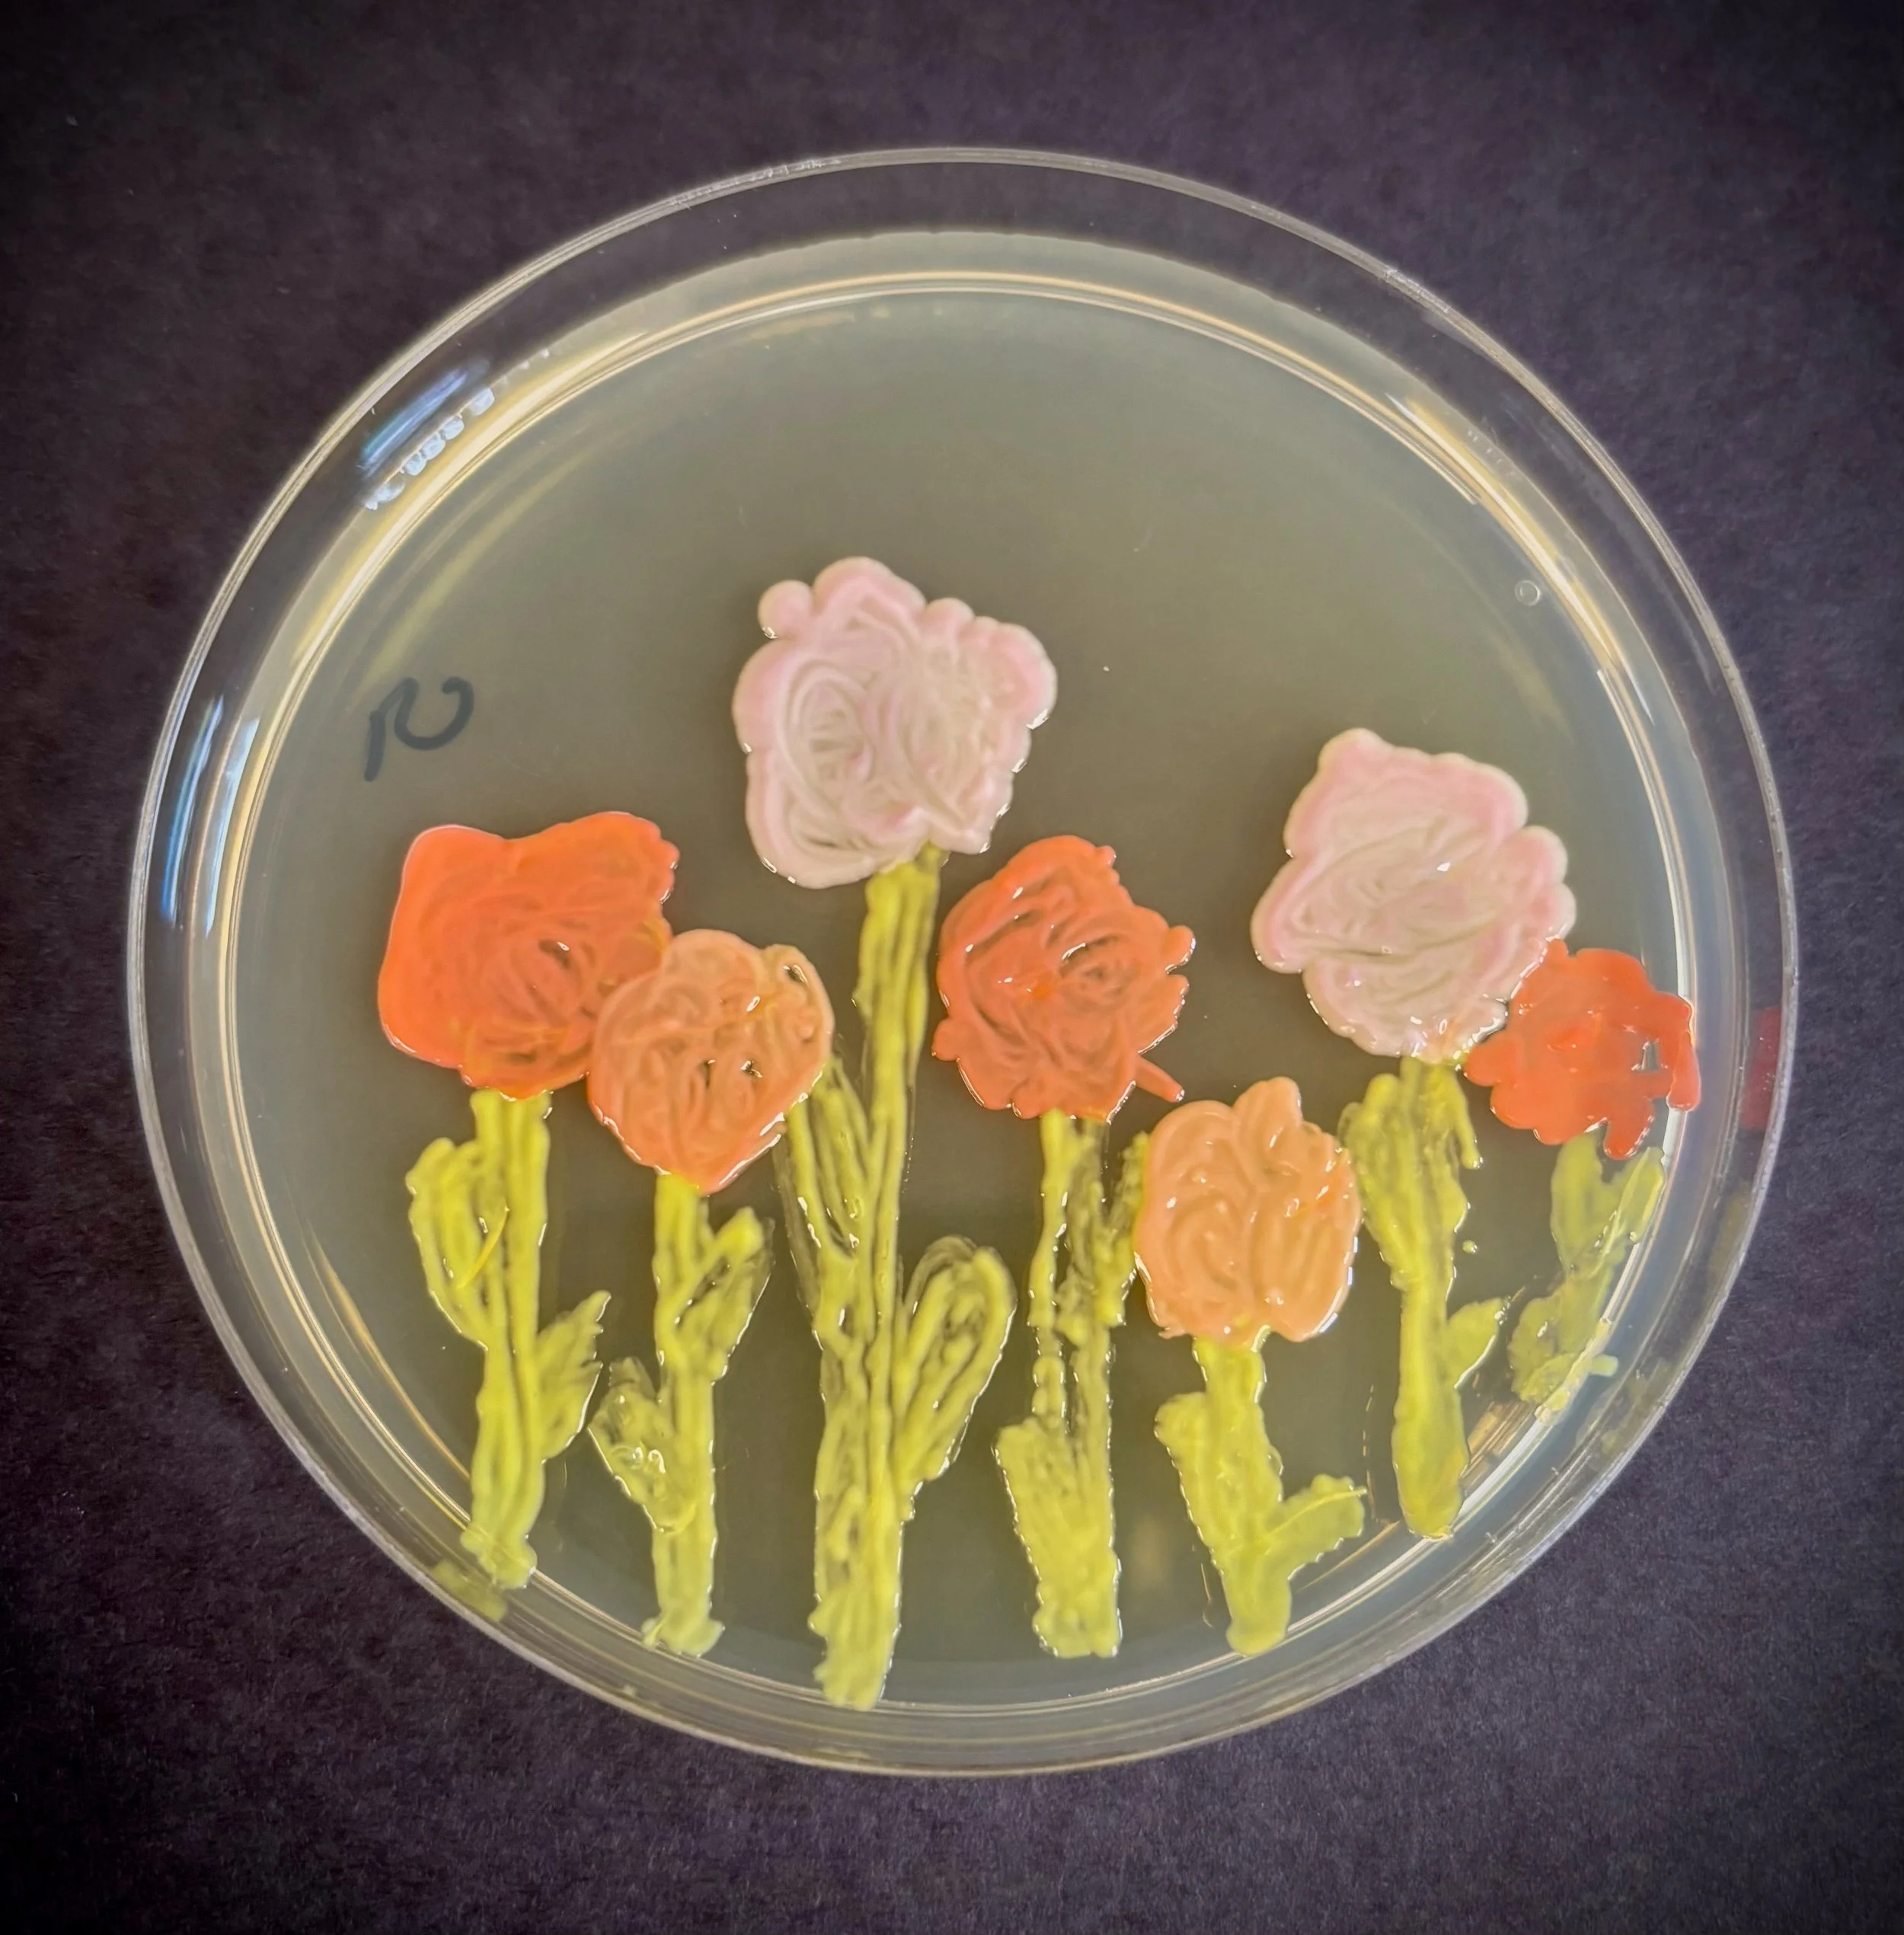
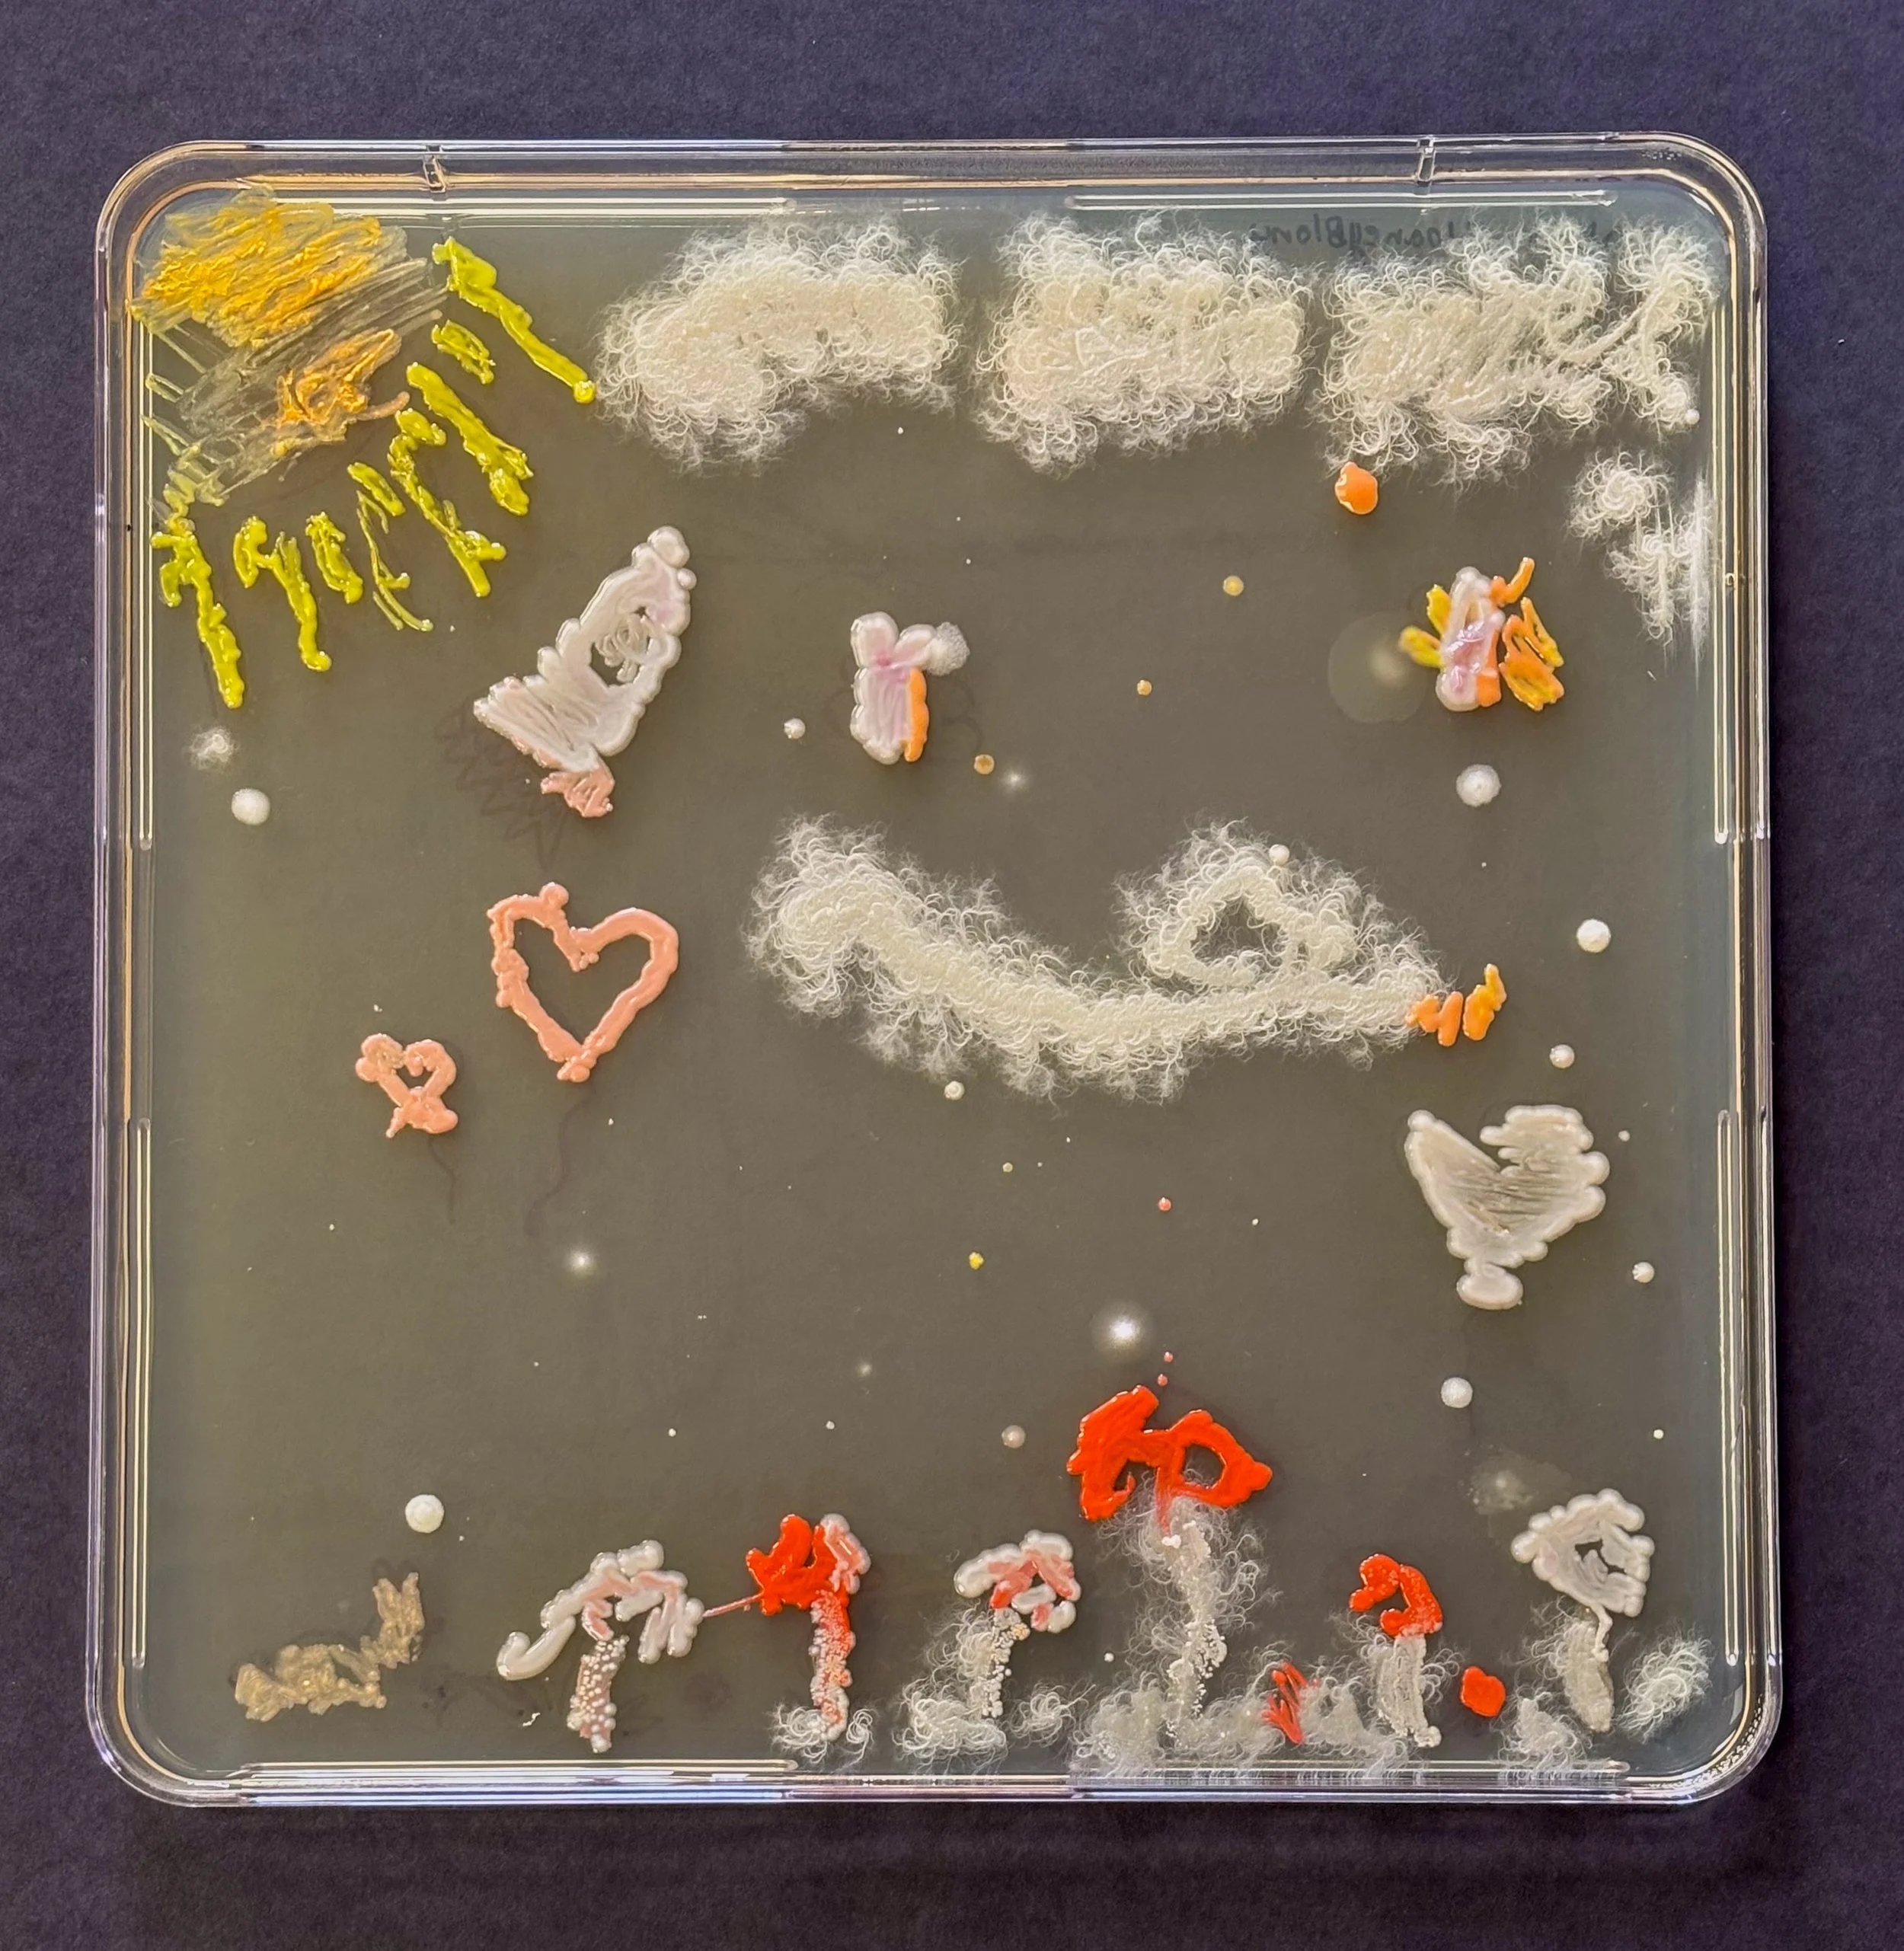

Bringing the Invisible to Life: Bacterial Art at GUS
Recently we welcomed Dr. Mehmet Berkmen, Senior Scientist at New England Biolabs, to campus for an engaging exploration of the connection between science and art.
Dr. Berkmen has long partnered with GUS Spanish and Fifth Grade Art Teacher Maria Peñil Cobo on the Bacterial Art Project, and last week they brought their work to GUS, inviting students to discover the links between scientific exploration and creative expression. Addressing a group of students from third to eighth grade, Dr. Berkmen encouraged them to rethink their view of microbes — not just as sources of illness, but as vital, creative forces that shape ecosystems worldwide. His presentation, supported by visual examples, demonstrated how living bacteria can serve as an artistic medium when grown on agar (a jelly-like substance made from seaweed), much like paint on a canvas. Dr. Berkmen’s and Ms. Peñil Cobo’s Bacterial Art Project emphasizes shared principles of scientific inquiry and artistic practice: experimentation, observation, growth, and even unpredictability.
After the presentation, fifth graders participated in a hands-on workshop to bring these ideas to life by creating their own bacterial art. As students worked, they experienced firsthand the balance of precision and creativity that defines both fields, fostering a deeper appreciation for the beauty and complexity of the microscopic world. These experiences reflect a broader approach to learning at GUS — one that encourages students to look closer, think across disciplines, and find meaning in their connections.
We are so grateful to Dr. Berkmen and Ms. Peñil Cobo for bringing this work to our campus—we look forward to continued collaboration ahead!